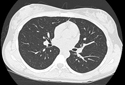
Computed Tomography (CT)

A CT scan is a diagnostic test that takes cross sectional pictures of the patient's internal anatomy. A CT scan creates highly detailed, cross sectional images of body parts and internal organs. CT can show bone and soft tissue structures such as internal organs, muscles, and blood vessels. It can be utilized to detect and diagnose a wide variety of medical conditions and abnormalities of nearly any body organ.�A CT scan may require a contrast media such as barium or IV contrast to better highlight abnormalities. These examinations are performed by certified technologists, and every examination is directly supervised and interpreted by board certified radiologists.
Frequently Asked Questions about Computed Tomography
 What is a CT scan?
What is a CT scan?
A CT scan is made up of a series of x-rays which are processed by a computer to produce cross-sectional pictures of the body. These cross-sectional images allow one to look at the inside of the body.
Are there any risks involved with CT scan?
During the CT scan, you are briefly exposed to radiation, so CT scan risks are similar to those of conventional X-rays.
What are Contrast Agents?
Contrast agents are used to image tissues and structures that are not normally seen, or not seen very well. Intravenous contrast agents are used to enhance organs and visualize blood vessels. Oral contrast agents may be given; these are used to visualize the digestive tract. If intravenous contrast is used, you may feel warm and flush and get a metallic taste in your mouth. These sensations normally disappear after a few minutes. Infrequently, hyper sensitive people may develop hives from the contrast.
Will I need to drink anything?
Most abdominal scans require the patient to drink an oral contrast or a barium sulfate mixture. This mixture is flavored and not at all unpleasant. Oral contrast highlights the stomach and upper intestine providing the radiologist with a detailed image for diagnosis.
Why do some patients need X-ray contrast and others not?
Depending upon your condition and the images required to diagnose or rule out pathology, X-ray dye or intravenous contrast may or may not be needed. The radiologist reviews the information sent to us by your physician and decides what contrast is needed to provide the best images.
What if I am allergic to X-ray contrast?
 If you have had a reaction to X-ray contrast in the past or have certain conditions such as asthma or COPD you may need to be treated before your exam with certain medications. Please advise the friendly staff at Houston MRI® so we can accommodate your medical needs.
If you have had a reaction to X-ray contrast in the past or have certain conditions such as asthma or COPD you may need to be treated before your exam with certain medications. Please advise the friendly staff at Houston MRI® so we can accommodate your medical needs.
What if I am diabetic?
You should continue your medicines as usual and drink extra juices prior to your exam in case you are not able to eat in a timely fashion. If you take Glucophage, you may take it the day of your exam, but if you receive IV X-ray contrast, you need to discontinue its use for 48 hours after the exam. You should contact your primary care physician regarding this matter.
How will I learn about my CT results?
The images from your examination will be interpreted by a one of our Radiologists who specialize in CT. The results of your examination will be communicated to your physician, who will discuss them with you.
CT Studies Offered:
CT Studies Offered:
- Head
- Sinus
- Chest
- Orbits
- Pelvis
- Abdomen
- Cervical Spine
- Thoracic Spine
- Lumbar Spine
- Soft Tissue Neck
- CT Angiogram
- Bones and Joints
Click here if you need to know more information about your exam

























